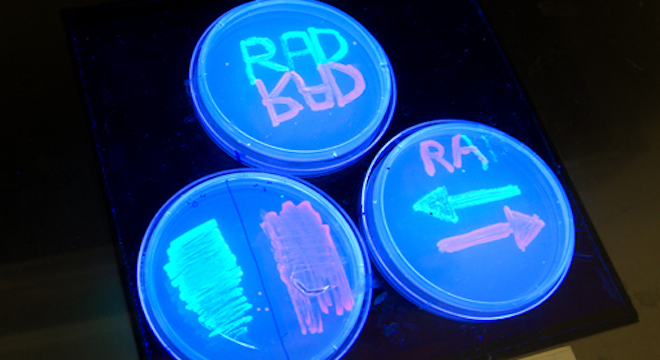

Forget saving files to flash drives and cloud servers. Now, digital information can be stored in the DNA of living organisms, thanks to a breakthrough discovery by researchers at Stanford University in California.
A trio of scientists successfully demonstrated the ability to flip the direction of DNA molecules in sample E.coli bacteria in two directions, mimicking the “1s” and “0s” of binary code, which is at the root of all modern computer calculations.
“Essentially, if the DNA section points in one direction, it’s a zero. If it points the other way, it’s a one,” said Pakpoom Subsoontorn, a bioengineering graduate student at Stanford involved in the research, in an article on the Stanford School of Medicine website.
As a result, the researchers were able to get bacteria cells to glow either red or green under ultraviolet light, and were even able to arrange the colors to spell out specific messages in petri dishes holding the bacteria. (Photo above)
The maximum total “file size” of the data stored using the method is currently restricted to one bit per cell, but the researchers are confident they can get it up to 8-bits, or one byte, of rewritable storage capacity by increasing the number of recombination enzymes within the data.
Their method, called recombinase addressable data (RAD), works because scientists are able to control the precise amount of enzymes that catalyze chemical reactions, within each of the single E.coli bacteria cells.
Specifically, the team used two types of enzymes, integrase and excisionase, in different amounts in each cell, to control the flipping of the DNA molecules.
It took a lot of hard work, though: Some 750 separate attempts over three years to get the right proportions of the enzymes to be able to flip the DNA “switches” as planned. That’s because the enzymes each tell the cell to do different things, so they are often competing for control. However, the researchers were able to achieve the right balance and produce the light show they sought.
Ultimately, the scientists believe RAD will be “an incredibly powerful tool for studying cancer, aging, organismal development and even the natural environment,” said Drew Endy, an assistant professor in Stanford’s bioengineering department, in the Stanford article.
As Endy, Subsoontorn and Stanford postdoc Jerome Bonnet further explained in a free-to-access paper published Tuesday in the The Proceedings of the National Academy of Sciences: “The DNA inversion RAD module developed here should be translatable to applications requiring stable long-term data storage (for example, replicative aging) or under challenging conditions (for example, clinical or environmental contexts…”

Stanford researchers Pakpoom Subsoontorn (left) and Jerome Bonnet show off their RAD method of storing digital data in DNA cells of living bacteria.